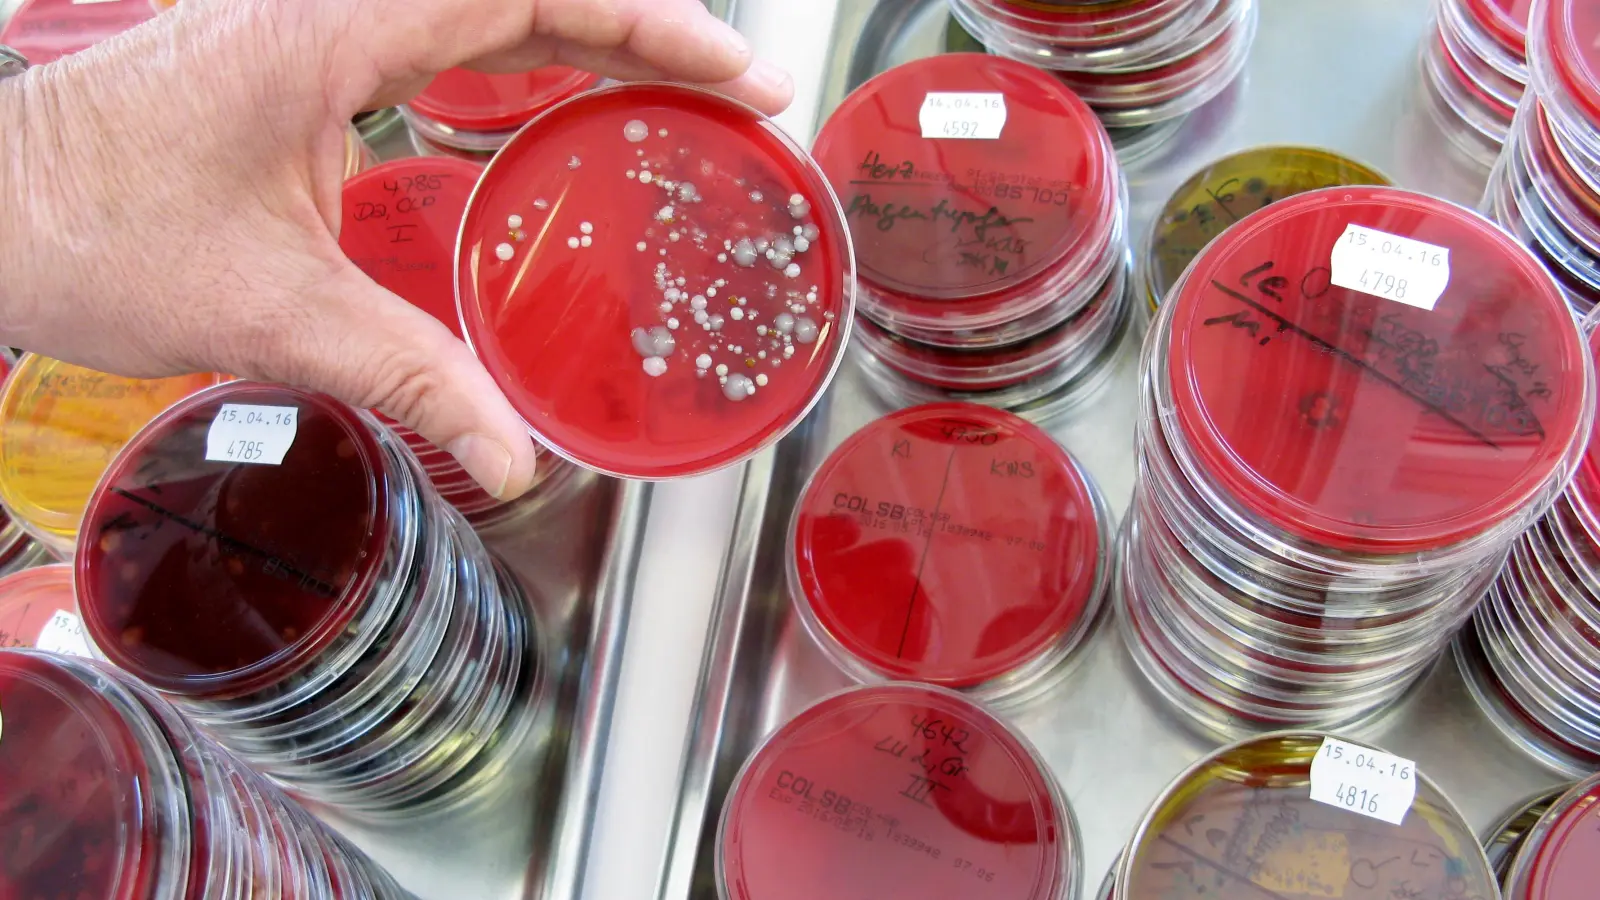
Das Landesamt für Gesundheit und Lebensmittelsicherheit hat im Zusammenhang mit einem Todesfall im Landkreis Schwandorf Proben untersucht. Nun liegen erste Ergebnisse vor.  (Symbolbild: Carolin Eckenfels/dpa)

Tortellini-Fall in Schwandorf: Bakterium nachgewiesen | Amberg24
Tortellini-Fall in Schwandorf: Bakterium nachgewiesen
Im „Tortellini-Fall” im Landkreis Schwandorf gilt nun ein Bakterium als Auslöser der Lebensmittelvergiftung.
Das Landesamt für Gesundheit und Lebensmittelsicherheit (LGL) hat erste Proben im Zusammenhang mit dem „Tortellini-Fall” analysiert. In den verarbeiteten Tortellini wurde das Bakterium bacillus cereus nachgewiesen. „Das Rohprodukt blieb ohne Befund”, teilte der Sprecher des Landratsamts, Manuel Lischka, auf Nachfrage von Oberpfalz-Medien am Donnerstag mit.
Das Bakterium kommt im Erdboden vor und kann Giftstoffe bilden, die zu Erbrechen und Durchfall führen. Das Bakterium gilt als Auslöser des „Fried Rice Syndrom”. Wenn Reis lange unter einer Temperatur von mindestens 60 Grad warmgehalten wird, können sich die Bakterien stark vermehren und giftige Stoffe bilden.
Mehrere Gäste einer Pizzeria im Landkreis Schwandorf klagten nach dem Verzehr von Tortellini über Erbrechen und starkes Unwohlsein. Eine 46-Jährige starb drei Tage nach dem Restaurantbesuch. Der Betreiber des Lokals hat die Pizzeria vorübergehend geschlossen. Die Staatsanwaltschaft Amberg hat nach Bekanntwerden des Vorfalls ein Verfahren wegen fahrlässiger Tötung und fahrlässiger Körperverletzung eingeleitet.